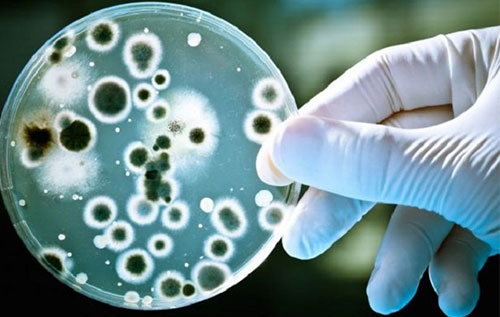

Dịch Vụ Vệ Sinh Môi Trường - đơn vị cung cấp sản phẩm - công nghệ vi sinh xử lý nước thải
Theo các chuyên gia, nước thải chứa hàng ngàn tấn chất hữu cơ, dầu mỡ... gây tác hại lớn đến môi trường và đời sống con người. Để đưa ra phương pháp xử lý kịp thời - hiệu quả nhằm bảo vệ môi trường sống, Dịch Vụ Vệ Sinh Môi Trường cung cấp vi sinh xử lý nước thải sinh hoạt, công nghiệp với mức phí hợp lý.
===============
Công Ty TNHH Hường Linh An
XỬ LÝ NƯỚC THẢI
CUNG CẤP VI SINH XỬ LÝ NƯƠC THẢI
CHI PHÍ NIÊM YẾT - CÓ HÓA ĐƠN.
CÔNG NGHỆ QUỐC TẾ
THÀNH CÔNG TRÊN 1000 DỰ ÁN.
⇛ 0933 908 908 ⇚
✔ Chúng tôi đang chờ phục vụ cho quý khách hàng!
===============
Vi sinh xử lý nước thải là gì?
Vi sinh xử lý nước thải (còn gọi là phương pháp xử lý sinh học) được hiểu đơn giản là quần thể những vi sinh vật sống, được nuôi cấy và chọn lọc có mục đích với chức năng xử lý các chất thải trước khi thải ra môi trường. Ở mỗi một môi trường nước thải khác nhau sẽ ứng dụng chủng vi sinh vật khác nhau.
Hiện nay có 2 phương pháp xử lý nước thải ở dạng vi sinh: Kỵ khí và hiếu khí
- Kỵ khí là phương pháp sử dụng nhóm vi sinh vật kỵ khí, hoạt động trong điều kiện không có oxy.
- Hiếu khí là phương pháp sử dụng nhóm vi sinh vật hiếu khí, hoạt động trong điều kiện cung cấp oxy liên tục.
Một loại vi sinh được ứng dụng trong nhóm vi sinh vật hiếu khí với chức năng xử lý nước thải
Thông thường, sự sinh trưởng và phát triển của vi sinh vật nằm ở điều kiện tốt nhất, đó là:
- Phụ thuộc vào các chất dinh dưỡng gồm Nito và phốt pho.
- Phụ thuộc vào hàm lượng chất hữu cơ có trong nước thải.
- Phụ thuộc vào nồng độ và lưu lượng oxy
- Phụ thuộc vào nhiệt độ nước thải, từ 25-37 độ C.
- Phụ thuộc vào nồng độ pH của nước thải, pH tối ưu từ 6,5-7,5.
Công Ty TNHH Hường Linh An chuyên cung cấp vi sinh xử lý nước thải đa dạng, phong phú
Sau nhiều năm cung cấp vi sinh xử lý nước thải cho hàng ngàn công ty lớn nhỏ, nhà máy, xí nghiệp, hộ gia đình... Công Ty Hường Linh An đã mang đến sự hài lòng tuyệt đối cho quý khách hàng. Với sự uy tín, hiệu quả và tiết kiệm tối đa chi phí đầu tư, khách hàng đã luôn tin tưởng và lựa chọn chúng tôi.
Để mang đến những giải pháp xử lý nước thải chuyên nghiệp nhất, ở một môi trường nước thải khác nhau chúng tôi sẽ tiến hành kiểm tra và đưa ra chủng vi sinh xử lý phù hợp. Cụ thể:

Xử lý nước thải bằng vi sinh dạng lỏng
❊ Vi sinh dạng lỏng
Đây là loại vi sinh nhân tạo được tổng hợp từ các nguồn vi sinh khác nhau ở dạng lỏng. Vi sinh dạng lỏng được nhiều khách hàng sử dụng nhờ tính hiệu quả và chất lượng nhất định.
Ưu điểm
- Xử lý hiệu quả các nguồn nước thải có hàm lượng cellulose cao.
- Giảm mùi hôi trong hệ thống xử lý nước thải.
- Vừa tăng sinh khối vừa sản xuất enzim.
- Thích nghi với mọi loại hình nước thải với thời gian sử dụng lâu dài.
Nhược điểm
- Chi phí cao
- Thời gian khởi động chậm so với bùn hoạt tính.
Xử lý nước thải bằng bùn vi sinh
❊ Bùn vi sinh
Là loại vi sinh thường được sử dụng trong quá trình nuôi cấy vi sinh. Bùn vi sinh được lấy từ bể chứa bùn hoặc bể lắng vi sinh của một hệ thống xử lý nước thải đang hoạt động.
Ưu điểm
- Tận dụng nguồn vi sinh ở một số hệ thống xử lý nước thải khác, vi sinh đã được kích hoạt sẵn.
- Thời gian nuôi cấy giảm, nếu đúng chủng loại vi sinh có trong bùn thì vi sinh sẽ phát triển rất nhanh chóng.
- Khởi động hệ thống nhanh, chi phí thấp.
Nhược điểm
- Phải bảo quản bùn vi sinh trong điều kiện cung cấp khí oxy.
- Dễ phát sinh sự cố trong bể sinh học.
- Không hiệu quả đối với 1 số loại hình nước thải khác.
Xử lý nước thải bằng vi sinh dạng bột
❊ Vi sinh dạng bột
Đây là loại vi sinh tồn tại dưới dạng bột rắn, chứa nhiều chủng vi sinh khác nhau ở chế độ chờ kích hoạt.
Ưu điểm
- Bảo quản và vận chuyển dễ nhờ vi sinh ở dạng bột, khối lượng nhẹ.
- Đa dạng vi sinh dạng bột, mỗi loại sẽ phù hợp với các loại nước thải khác nhau.
- Thân thiện với môi trường và không gây chết các sinh vật sống dưới nước.
Nhược điểm
- Mất nhiều thời gian kích hoạt và thích nghi với nước thải.
- Giá thành cao.
- Yêu cầu phải bổ sung thường xuyên.
- Không thể nhân sinh khối.
Như vậy, mỗi một loại vi sinh xử lý nước thải có ưu và nhược điểm khác nhau. Nếu quý khách hàng cần một sản phẩm vi sinh hiệu quả và đúng với mong muốn sử dụng có thể liên hệ với Công Ty Hường Linh An, chúng tôi chuyên bán sản phẩm vi sinh xử lý nước thải với chất lượng tối ưu kèm theo mức phí hợp lý.

Dịch Vụ Vệ Sinh Môi Trường cung cấp dịch vụ vận chuyển bùn vi sinh giá rẻ
Bên cạnh đó, chúng tôi còn cho thuê xe chở bùn vi sinh và nhận hút bùn vi sinh theo yêu cầu. Mọi thông tin chi tiết vui lòng liên hệ đến hotline 0933 908 908 để được tư vấn cụ thể hơn.
Một số dự án cung cấp vi sinh xử lý nước thải tại Công Ty Hường Linh An
Nhờ sở hữu đội ngũ nhân viên năng động, trình độ chuyên môn cao Công Ty Hường Linh An đã giúp nhiều khách hàng xử lý nhanh chóng tình trạng nước thải. Dưới đây là một số công trình mà chúng tôi đã tư vấn, thiết kế và thi công hệ thống xử lý nước thải cho tất cả các ngành nghề:

Cung cấp, vận chuyển nuôi cấy bùn vi sinh hoạt tính 270 tấn cho công ty Dệt.

Cung cấp giải pháp xử lý nước thải bằng vi sinh dạng bột với khối lượng 2 kg chế phẩm trên 1000m2 bề mặt nước thải hàng tháng cho khu công nghiệp Hòa Hưng tại Quảng Nam.

Cung cấp vi sinh dạng lỏng có tính năng hoạt động mạnh gấp 5 đến 10 lần vi sinh thông thường. Chuyên dùng giảm BOD, COD, TSS cho nước thải đa ngành như: công nghiệp, nước thải sinh hoạt đô thị, ngành cao su, dệt nhuộm… cho một số công ty và khu công nghiệp trên địa bàn Đà Nẵng.

Cung cấp, vận chuyển nuôi cấy bùn vi sinh hoạt tính 340 tấn cho bệnh viện.
Công Ty Hường Linh An cam kết sẽ giải quyết những khó khăn, vướng mắc của tất cả các khách hàng khi có nhu cầu xử lý nước thải bằng công nghệ hiện đại và dễ vận hành nhất. Hãy liên hệ với chúng tôi bằng cách:
Gọi đến hotline 0933 908 908


